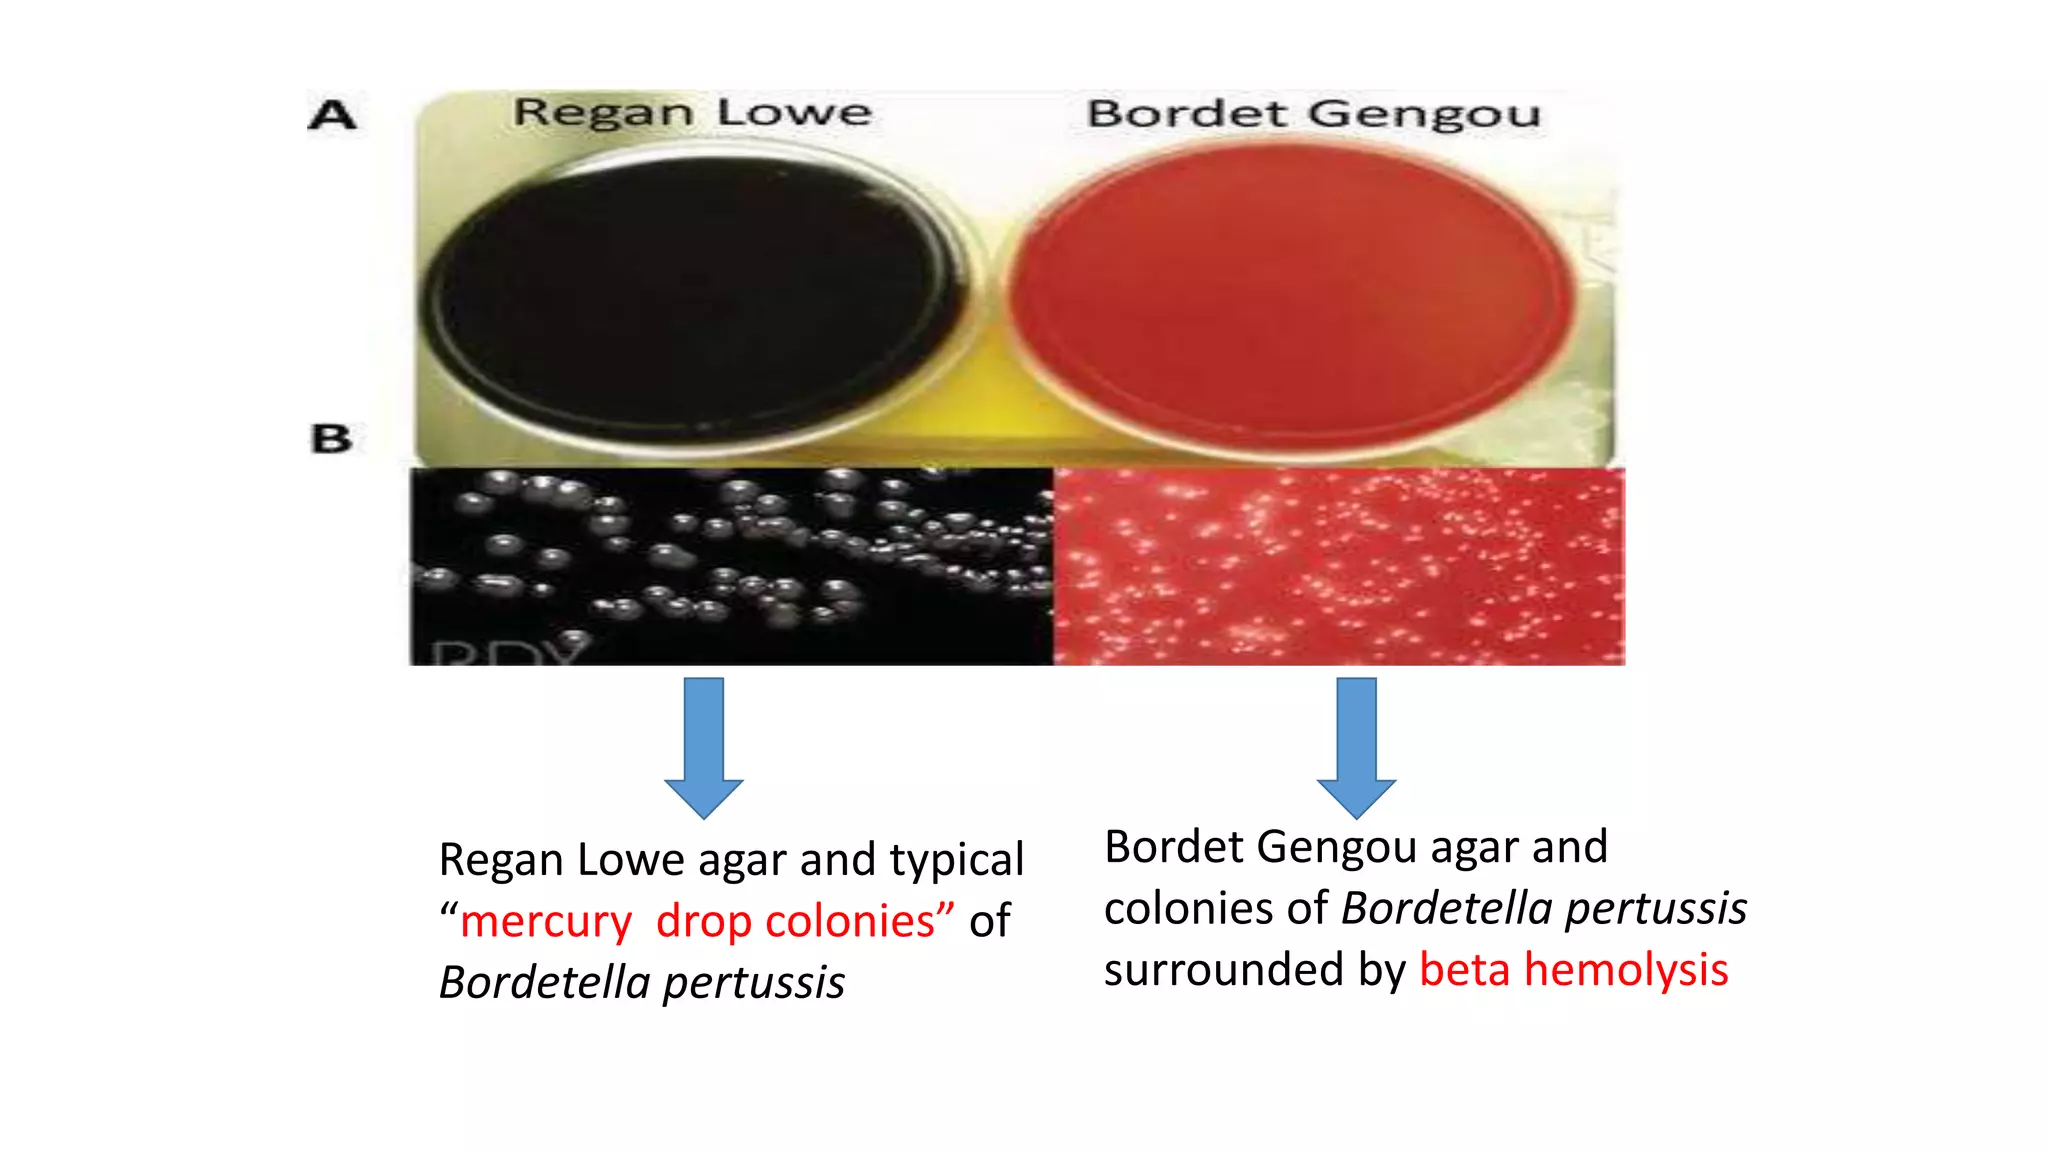
Regan Lowe agar and typical
“mercury drop colonies” of
Bordetella pertussis
Bordet Gengou agar and
colonies of Bordetella pertussis
surrounded by beta hemolysis
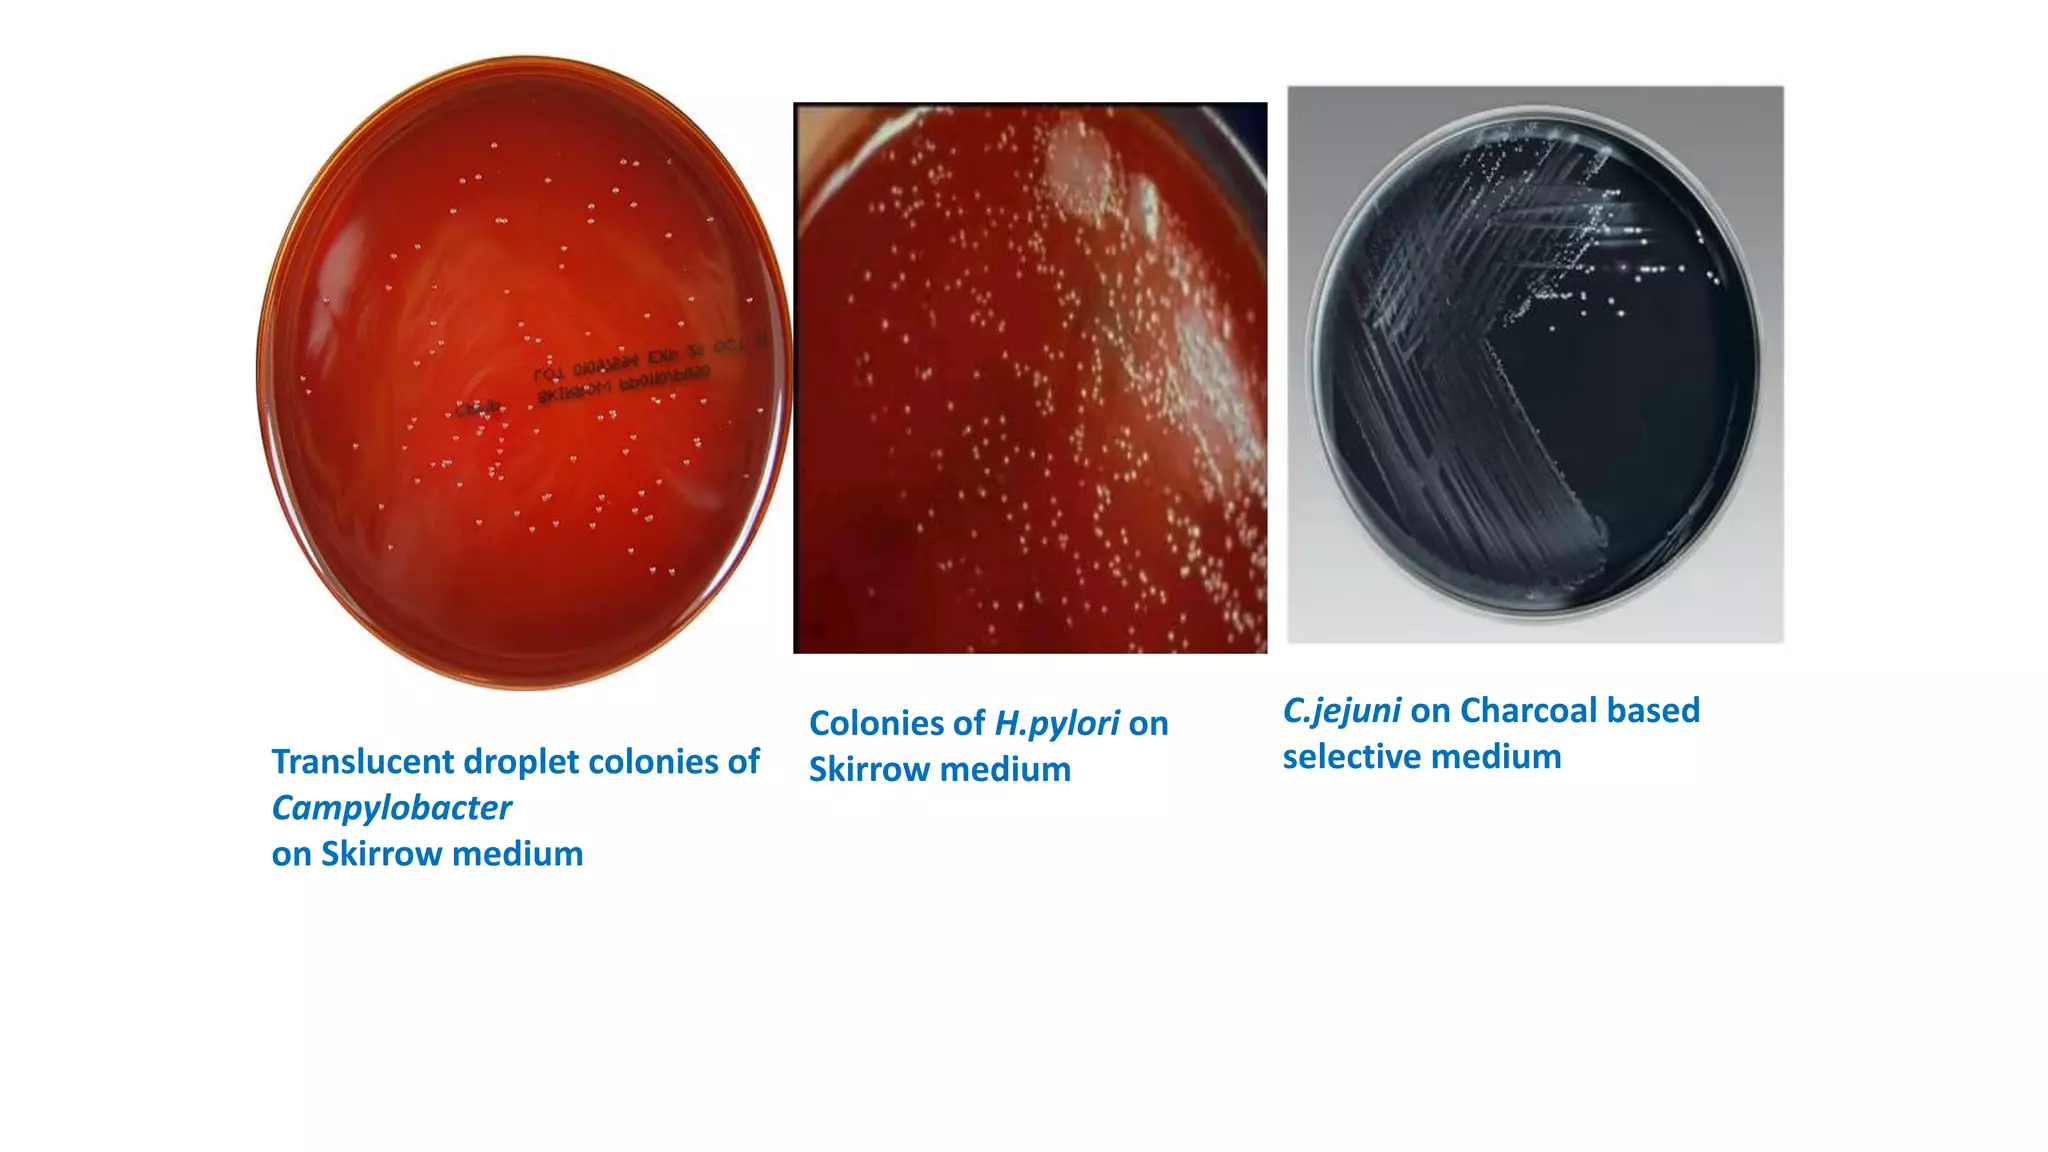
Translucent droplet colonies of
Campylobacter
on Skirrow medium
Colonies of H.pylori on
Skirrow medium
C.jejuni on Charcoal based
selective medium

1. The document discusses various culture media used for cultivating microorganisms from clinical specimens. It describes the composition and purpose of different types of media including basal media, enriched media, selective media, and transport media.
2. Specific media are described for cultivating gram positive cocci like Staphylococci and Streptococci. Mannitol salt agar, tellurite glycine agar, and DNase test agar are discussed for isolating and identifying Staphylococcus. Todd Hewitt broth and crystal violet blood agar are mentioned for Streptococci.
3. Modified Thayer Martin medium and modified New York City medium are highlighted as selective media used for isolating Neisseria